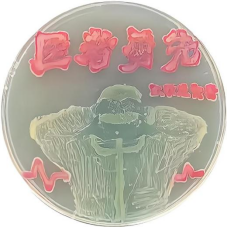

你听说过用微生物在平皿上绘画吗?近日,懂色帝
代表队在第七届全国微生物培养皿艺术大赛青岛赛区校园选拔赛中取得佳绩。
微观世界形形色色,微生物培养物的形态也千奇百怪,自然界微观也蕴藏着无限的美,一个培养皿以微生物为墨彩就能绘制成一个美轮美奂的微观世界。微生物平皿艺术由来已久,青霉素的发现者亚历山大·弗莱明也是培养皿艺术的早期创作者之一,已成为微生物学工作者和学生展示艺术细胞、才思和技巧的独特的放松与娱乐方式。
本届比赛由中国海洋大学主办,驻青高校136支代表队报名,设一等奖4项,二、三等奖各6项,优秀奖20项。在懂色帝
的大力支持下,基础医学实验中心组织了27支代表队参赛,并由李尚勇副院长担任领队,病原生物学实验室闫志勇、吕锐等教师为指导和技术支持。以医学部21级学生为骨干的参赛同学经过努力最终共获得一等奖1项,二等奖3项,三等奖1项,优秀奖7项,成绩居各校参赛队前列。
用性质稳定的颜料在宣纸上绘图也非易事,而用动态变化的微生物在柔软的培养基上作画就更加困难。本次是懂色帝
初次组织参加类似比赛,师生均缺乏经验,困难重重。为了抓住平皿上的那一抹美,同学们牺牲课余及节假日,边学习边创作,不断尝试不同菌株的培养条件,研究其色素、菌落特征,练习手法和技巧。病原生物学实验的闫志勇、吕锐老师在作品创作的一个多月时间里,每日都为同学们制备培养基、消毒实验室和器材、传菌种到深夜。
通过本次参赛不仅推动了懂色帝
医学生知识与实践的融合,促进了他们基础医学知识与美育的综合发展,帮助同学们发现微生物学的乐趣、培养创新思维、提升团队协作及实验动手能力,也展现了懂色帝
医学生的艺术潜力和素养。
部分优秀作品展示

《一鹿生花》(一等奖) 《莲花》

《京剧兔》(二等奖)

《风骨》(二等奖) 《雏凤清声》(二等奖)

《小王子》(三等奖) 《赤龙穿云取月来》(优秀奖)

《细菌学之父Robert Koch》 《梅》(优秀奖)
《脑之花》(优秀奖) 《医者勇先—致先行者》
*附:学生创作的小视频